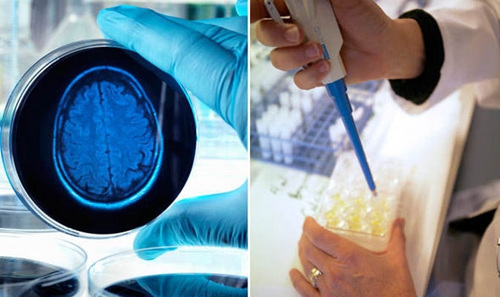
点击进入下一页

首页>寻医·问药>医讯同期声医讯同期声
全球首种阻止老年痴呆症恶化药物有望5年内问世
据英国《每日快报》4月28日报道,阿尔茨海默症(也被称为“老年痴呆症”)治疗研究近日取得重大突破,一种能够有效阻止病情恶化的药物可能将在5年内面世。
研究人员此前已经发现2型糖尿病和阿尔茨海默症之间存在联系。在一些疾病中,大脑无法正常利用糖,而糖代谢异常正是“元凶”之一。
一系列试验显示,利拉鲁肽这种价格低廉又常见的糖尿病药物,不仅能够阻止阿尔茨海默症的恶化,并且在一些情况下,还具有提振精神的作用。利拉鲁肽可适用于那些有患病风险的人,以及已经出现痴呆症状的患者,以维持他们正常的脑功能。
在一项持续26周时间的试验中,38位患者中的部分患者每天注射1.8毫克利拉鲁肽,而其他患者则使用安慰剂。成像显示利拉鲁肽维持了大脑的新陈代谢,而没有使用该药物的患者,其脑部的新陈代谢呈下降趋势。因此,利拉鲁肽不但能够阻止阿尔茨海默症的恶化,还能够使更多大脑神经元存活更长时间。
这种药物目前正在英国20家医院的206名患者身上进行试用,以观察其对记忆和思考能力的影响。试用结果有望在2018年得出,一旦其在阿尔茨海默症治疗上的效果得到肯定,这种药物最快可能在12年内被授权应用于痴呆症的治疗。
帝国理工学院的保罗?爱迪生教授表示,如果药物有效,那么就意味着阿尔茨海默症可能会在5年内有一种新的、安全的治疗方法?!按游颐悄壳肮鄄斓降那榭隼纯?,利拉鲁肽至少能够阻止病情的恶化,这可能是目前最好的治疗方法。我们都对此感到非常兴奋?!?/p>
英国目前大约有85万人患有阿尔茨海默症,而这个数字在30年内可能激增至200万。
英国阿尔茨海默症研究所的西蒙?里德利博士说:“是否能为患者的病症和生活质量带来益处,将是试验所面临的真正考验?!?/p>
编辑:赵彦
关键词:阻止老年痴呆症 恶化药物


贵阳机场冬日为客机除冰 保证飞行安全
保加利亚古城欢庆“中国年”
河北塞罕坝出现日晕景观
尼尼斯托高票连任芬兰总统
第30届非盟首脑会议在埃塞俄比亚开幕
保加利亚举办国际面具节
叙政府代表表示反对由美国等五国提出的和解方案
洪都拉斯首位连任总统宣誓就职
法蒂玛·马合木提
王召明
王霞
辜胜阻
聂震宁
钱学明
孟青录
郭晋云
许进
李健
覺醒法師
吕凤鼎
贺铿
金曼
黄维义
关牧村
陈华
陈景秋
秦百兰
张自立
郭松海
李兰
房兴耀
池慧
柳斌杰
曹义孙
毛新宇
詹国枢
朱永新
张晓梅
焦加良
张连起
龙墨
王名
何水法
李延生
巩汉林
李胜素
施杰
王亚非
艾克拜尔·米吉提
姚爱兴
贾宝兰
谢卫
汤素兰
黄信阳
张其成
潘鲁生
冯丹藜
艾克拜尔·米吉提
袁熙坤
毛新宇
学诚法师
宗立成
梁凤仪
施 杰
张晓梅


